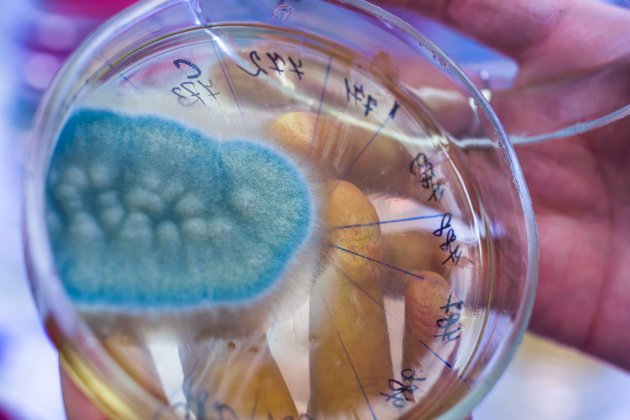

Aflatoksin Nedir ve Zararları Nelerdir?
Günümüzde gıda güvenliği yalnızca üretim aşamasıyla kısıtlı değildir; depolama, taşıma ve tüketim süreçleri de insan sağlığını doğrudan etkileyen riskler içermektedir. Bu risklerden biri olan aflatoksin, gözle görülmeyen ancak son derece tehlikeli bir tehdittir. Doğal olarak oluşmasına rağmen ciddi sağlık sorunlarına yol açabilen bu madde, özellikle uygun olmayan saklama koşulları sebebiyle gıdalarda meydana gelir.
Aflatoksin Nedir?
Aflatoksin, Aspergillus flavus ve Aspergillus parasiticus gibi bazı küf türleri tarafından üretilen toksik ve kanserojen bir bileşiktir. Bu küfler genellikle sıcak, nemli ve kötü depolama koşullarında gelişir. Aflatoksin, fıstık, mısır, ceviz, badem ve incir gibi tarımsal ürünlerde yaygın olarak bulunabilir. Gıda zinciri aracılığıyla hayvanlara ve insanlara geçiş yapabilir. Aflatoksin B1, bilinen en güçlü doğal kanserojenlerden biri olup, karaciğer kanseri de dahil olmak üzere ciddi sağlık sorunlarına neden olabilir.
Aflatoksinler hem gıdalarda hem de hayvan yemlerinde bulunabilir ve dolaylı olarak süt, et ve yumurta gibi hayvansal ürünlere geçebilir. Bu nedenle, hem insan sağlığı hem de hayvancılık açısından önemli bir risk faktörü oluşturur. Gıda güvenliği alanında, aflatoksin kontrolü ve tespiti büyük önem taşır. Uluslararası sağlık otoriteleri, aflatoksin seviyelerinin kontrol altında tutulması için sıkı düzenlemeler uygulamaktadır.
Aflatoksin Zararları Nelerdir?
Aflatoksinlerin en önemli tehlikesi, karaciğeri hedef alan toksik etkileridir. Özellikle aflatoksin B1, karaciğer hücrelerinde DNA yapısını bozarak kanserleşmeye neden olan mutasyonlara yol açabilir. Uzun süreli ve düşük düzeyde aflatoksin maruziyeti, karaciğer sirozu, karaciğer kanseri, bağışıklık sistemi zayıflığı, büyüme geriliği ve doğurganlık sorunlarına neden olabilir. Akut yüksek doz alımı, karaciğer yetmezliği, mide-bağırsak kanamaları ve ölümle sonuçlanabilir.
Özellikle bebekler, küçük çocuklar, yaşlılar ve bağışıklığı zayıflamış bireyler, aflatoksinlerin zararlı etkilerine karşı daha hassastır. Gıdaların uygun şekilde saklanmaması ve aflatoksin bulaşmış ürünlerin tüketilmesi bu riskleri artırır.
Aflatoksinin başlıca zararları şunlardır:
- Karaciğer Kanseri: Aflatoksin B1, karaciğer hücrelerinde DNA hasarı yaparak kanserleşmeye neden olabilir.
- Bağışıklık Baskılanması: Vücudun enfeksiyonlara karşı direnci azaltabilir.
- Gelişim Geriliği: Çocuklarda büyüme ve gelişim üzerinde olumsuz etkiler yaratabilir.
- Üreme Sorunları: Kısırlık, düşük yapma ve sperm kalitesinde azalma gibi etkiler oluşturabilir.
- Karaciğer Yetmezliği: Özellikle yüksek doz maruziyetlerinde ölümcül olabilir.
- Gastrointestinal Problemler: Bulantı, kusma, ishal ve mide kanamaları görülebilir.
- Genetik Hasar: DNA yapısında kalıcı bozulmalar oluşabilir.
- Sinir Sistemi Üzerinde Etki: Nörolojik rahatsızlıklara yol açabilir.
- Hayvanlarda Verim Kaybı: Süt ve et veriminde düşüş, hastalık direncinin azalması görülebilir.
- Yiyecek Güvenliği Riski: Gıdaların kontaminasyonu sonucunda halk sağlığı tehdit altına girer.
Aflatoksin Nasıl Oluşur?
Aflatoksin oluşumunun biyolojik süreci, çevresel faktörlerin etkisiyle başlar. Küf mantarlarının gelişimi için uygun sıcaklık, nem ve oksijen düzeyleri kritik öneme sahiptir. Bu mantarlar, hasat sonrası yeterince kurutulmamış veya havalandırılmamış ürünlerde hızla çoğalır. Aflatoksin üretimi, mantarların besinleri parçalayıp üreme ortamı oluşturduğu metabolik süreçlerin bir yan ürünü olarak ortaya çıkar. Bu toksinler, yalnızca gıda ürünlerinde değil, depolama sırasında kullanılan çuvallar, raf sistemleri ve konteynerlerde de kalıcı olarak bulunabilir; bu durum bulaşma riskini artırır.
Ayrıca, mantarların aflatoksin üretimi, ürün türü, genetik yapısı ve yetiştiği toprağın kimyasal bileşimi gibi birçok faktöre bağlı olarak farklılık gösterir. Bu nedenle tarımsal üretim sürecinde hijyenin yanı sıra tohum seçimi ve gübreleme gibi birçok faktör dikkate alınmalıdır. Ülkemizde ve dünya genelinde aflatoksinle mücadele, yalnızca laboratuvar testleri ile değil; çiftçilerin bilinçlendirilmesi, teknolojik altyapının güçlendirilmesi ve tüketicilerin bilgilendirilmesi ile de gerçekleştirilebilir.
Aflatoksinler, küf mantarlarının metabolik faaliyetleri sonucunda üretilmektedir. Özellikle sıcaklık 25-32°C arasında ve nem %70’in üzerinde olduğunda Aspergillus türleri hızla çoğalır ve toksin üretir. Hasat sonrası ürünlerin açıkta bırakılması, nemli ortamlarda depolanması ve hijyenik olmayan koşullarda saklanması aflatoksin oluşumunu kolaylaştırmaktadır. Mısır, yer fıstığı, ceviz, kuru yemişler ve kuru incir gibi ürünler yüksek risk taşımaktadır.
Aflatoksin oluşumu, hasat sırasında başlayabilir ve uygun kurutma yapılmadığı takdirde depolama süresince devam edebilir. Ayrıca, aflatoksin bulaşmış hayvan yemleriyle beslenen hayvanlardan elde edilen süt ve yumurta gibi ürünlerde de bu toksin mevcut olabilir. Bu nedenle, üretimden tüketime kadar tüm zincirde sıkı denetim ve izleme gerekmektedir. Aflatoksin oluşumunu önlemek için iyi tarım uygulamaları, hasat sonrası doğru kurutma teknikleri ve kontrollü depolama koşulları son derece önemlidir.
Son güncellenme tarihi: 23 Eylül 2025
Yayınlanma tarihi: 23 Eylül 2025



